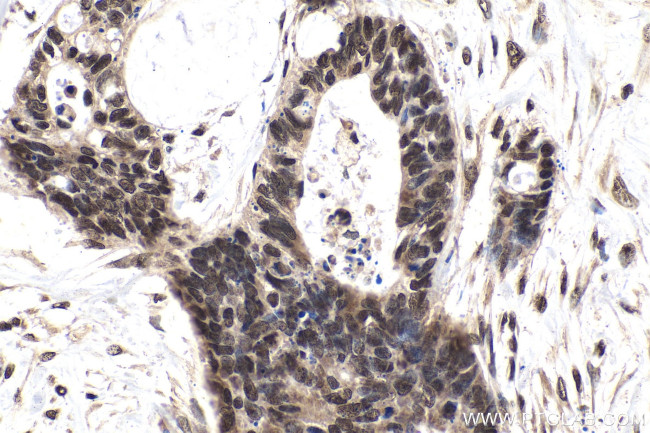
TIA1 Antibody in Immunohistochemistry (Paraffin) (IHC (P))

Search
Proteintech
TIA1 Monoclonal Antibody (2C11F4)
{{$productOrderCtrl.translations['antibody.pdp.commerceCard.promotion.promotions']}}
{{$productOrderCtrl.translations['antibody.pdp.commerceCard.promotion.viewpromo']}}
{{$productOrderCtrl.translations['antibody.pdp.commerceCard.promotion.promocode']}}: {{promo.promoCode}} {{promo.promoTitle}} {{promo.promoDescription}}. {{$productOrderCtrl.translations['antibody.pdp.commerceCard.promotion.learnmore']}}
产品信息
68486-1-IG
种属反应
宿主/亚型
分类
类型
克隆号
抗原
偶联物
形式
浓度
纯化类型
保存液
内含物
保存条件
运输条件
产品详细信息
Immunogen sequence: MEDEMPKTLY VGNLSRDVTE ALILQLFSQI GPCKNCKMIM DTAGNDPYCF VEFHEHRHAA AALAAMNGRK IMGKEVKVNW ATTPSSQKKD TSSSTVVSTQ RSQDHFHVFV GDLSPEITTE DIKAAFAPFG RISDARVVKD MATGKSKGYG FVSFFNKWDA ENAIQQMGGQ WLGGRQIRTN WATRKPPAPK STYECRCIGE EKEMWNFGEK YARF
靶标信息
Noggin is involved in numerous developmental processes, such as neural tube fusion and joint formation. The morphogenesis of organs is initiated by a downgrowth from a layer of epithelial stem cells. This process is achieved through the receipt of signals from 1) a WNT protein (WNT3A) to stabilize beta-catenin; and 2) Noggin, which is a bone morphogenetic protein inhibitor. Noggin mutations in unrelated families with proximal symphalangism (SYM1) and multiple synostoses syndrome (SYNS1) have been identified, which have multiple joint fusion as their principal defect.
仅用于科研。不用于诊断过程。未经明确授权不得转售。
篇参考文献 (0)
生物信息学
蛋白别名: Cytotoxic granule associated RNA binding protein TIA1; cytotoxic granule-associated RNA binding protein 1; cytotoxic granule-associated RNA-binding protein 1; Nucleolysin TIA-1; Nucleolysin TIA-1 isoform p40; p40 TIA 1; p40-TIA-1; p40-TIA-1 (containing p15-TIA-1); RNA-binding protein TIA-1; T-cell-restricted intracellular antigen-1; TIA 1; TIA-1; TIA1 protein; TIAL1; TIAR
基因别名: 2310050N03Rik; AI256674; mTIA-1; Tia; TIA-1; TIA1; WDM
UniProt ID: (Human) P31483, (Mouse) P52912
Entrez Gene ID: (Human) 7072, (Rat) 312510, (Mouse) 21841